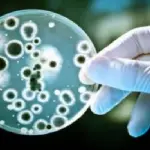
Batterio degli incubi colpisce donna in Pennsylvania: resiste al colistin

Esteri

Zurich, ex CEO Martin Senn si è suicidato
Redazione - 30 mag 2016

Fulmini in Francia: 3 bimbi in pericolo di vita
Redazione - 29 mag 2016


Airbus 320 Egyptair colpito da asteroide?
Redazione - 26 mag 2016

Bill Cosby subirà processo penale per stupro
Redazione - 25 mag 2016